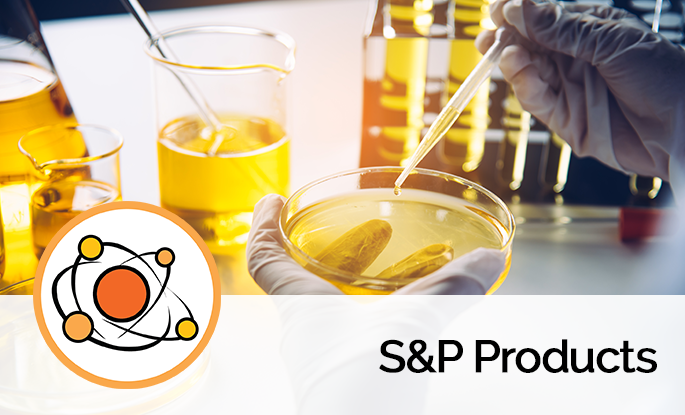
S&P Products

My Cart
0
You have no items in your shopping cart.
 S&P Products
S&P Products Imaging & PET
Imaging & PET Isotopic Gases & Metals
Isotopic Gases & Metals NMR Accessories
NMR Accessories NMR Consumables
NMR Consumables Stable Isotopes for NMR
Stable Isotopes for NMR Biomolecular NMR
Biomolecular NMR Materials Science
Materials Science Metabolomics
Metabolomics Organic Chemistry
Organic Chemistry Stable Isotopes for MS
Stable Isotopes for MS Stable Isotopes for Electronics
Stable Isotopes for Electronics Stable Isotopes for Pharmaceuticals
Stable Isotopes for Pharmaceuticals Stable Isotopes & Services
Stable Isotopes & Services NMR Consumables & Accessories
NMR Consumables & Accessories Stable Isotopes for NMR & MS
Stable Isotopes for NMR & MS Unlabeled Compounds
Unlabeled Compounds S&P Products
S&P Productsfor all domains of tomorrow
the best brands sold for our future
do you want to know more ?
FedEx, DHL, TNT
in Europe, America & Asia
payments, RFQ, purchase orders